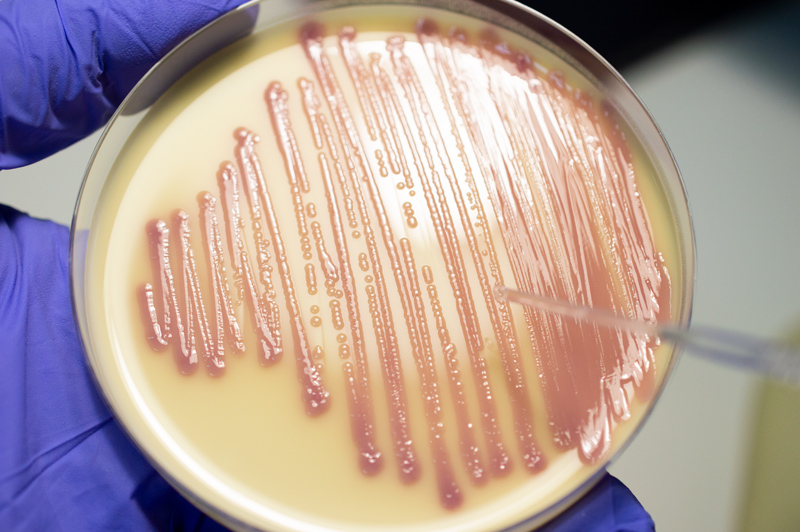

Кишечная палочка — це бактерія, яка природно живе у кишечнику людини та тварин. Вона відіграє важливу роль у травленні, однак певні штами можуть викликати серйозні інфекційні захворювання. Найбільш небезпечні види цієї бактерії можуть призвести до харчових отруєнь, інфекцій сечових шляхів і навіть запалення нирок.
Види бактерії кишечная палочка
Існують різні штами бактерії, серед яких корисні й патогенні. Корисна кишечная палочка допомагає синтезувати вітаміни, наприклад, вітамін K, та підтримує здорову мікрофлору кишечника. Проте патогенні штами, такі як E. coli O157:H7, виробляють токсини, що викликають важкі отруєння та інфекції.
Як передається кишечная палочка
Кишечная палочка передається найчастіше через забруднену їжу або воду. Наприклад, сире м’ясо, непастеризоване молоко чи немиті овочі можуть бути джерелом інфекції. Крім того, зараження може статися через контакт із хворою людиною або через недотримання правил гігієни, особливо після відвідування туалету.
Симптоми зараження кишечной палочкой

Перші симптоми з’являються зазвичай через кілька годин або днів після потрапляння бактерії в організм. Найпоширеніші прояви — це болі в животі, нудота, блювання, підвищення температури і діарея. У важких випадках можуть з’явитися кров’янисті випорожнення, що свідчить про ураження слизової кишечника.
Ускладнення, які може викликати кишечная палочка
Деякі штами бактерії можуть викликати небезпечні ускладнення. Наприклад, гемолітико-уремічний синдром, який вражає нирки і може стати загрозливим для життя. Особливо ризикують діти, літні люди та ті, у кого ослаблена імунна система.
Діагностика інфекції кишечной палочки
Для виявлення інфекції лікар призначає лабораторні аналізи калу, сечі або крові. У цих дослідженнях визначається наявність бактерії та її тип. У разі підозри на серйозне ураження нирок або інших органів можуть проводитися додаткові обстеження.
Лікування інфекції, спричиненої кишечной палочкой
Лікування залежить від форми інфекції та її тяжкості. У більшості випадків призначається рясне пиття, дієта і відпочинок. Антибіотики застосовують лише за рекомендацією лікаря, оскільки деякі штами можуть бути стійкими до ліків. У разі сильної інтоксикації може знадобитися госпіталізація.
Профілактика зараження кишечной палочкой
Щоб уникнути інфекції, важливо дотримуватися гігієни. Необхідно ретельно мити руки перед їжею, мити овочі та фрукти, добре готувати м’ясо та уникати вживання сирого молока. Також варто стежити за чистотою питної води.
Кишечная палочка і дитячий організм
У дітей інфекції, викликані цією бактерією, часто протікають важче. Малюки швидко втрачають рідину, тому їм потрібно більше пити. Якщо з’являється блювання або пронос, слід негайно звернутися до педіатра.
Кишечная палочка у сечовидільній системі
Бактерія може потрапляти і в сечовидільну систему, викликаючи запалення сечового міхура або нирок. Найчастіше це трапляється у жінок через особливості будови організму. Симптомами є біль під час сечовипускання, часті позиви та відчуття тяжкості внизу живота.
Народні методи лікування кишечной палочки
Хоча народні засоби не можуть замінити медикаментозне лікування, вони можуть допомогти зменшити симптоми. Наприклад, настої ромашки або календули мають протизапальну дію. Однак використовувати їх слід лише після консультації з лікарем.
Кишечная палочка та імунна система
Сильний імунітет допомагає організму швидше впоратися з інфекцією. Для цього важливо вести здоровий спосіб життя, правильно харчуватися, уникати стресу і висипатися. Також корисно вживати продукти, що містять пробіотики, наприклад йогурти.
Як уникнути повторного зараження кишечной палочкой
Повторне зараження може статися, якщо не дотримуватися правил гігієни. Не можна вживати напівсире м’ясо або непастеризовані молочні продукти. Також важливо мити руки після контакту з тваринами.
Кишечная палочка у продуктах харчування
Найчастіше бактерію виявляють у м’ясних продуктах, молоці та сирих овочах. Харчові компанії проводять контроль якості, щоб уникнути зараження. Однак споживачам також потрібно бути уважними і зберігати продукти при правильній температурі.
Чому кишечная палочка небезпечна під час вагітності
Під час вагітності організм стає більш вразливим до інфекцій. Кишечная палочка може викликати запалення сечового міхура або навіть вплинути на розвиток плоду. Тому майбутнім мамам потрібно уважно стежити за гігієною і при найменших симптомах звертатися до лікаря.
Кишечная палочка у тварин
Домашні тварини також можуть бути носіями бактерії. Важливо регулярно проводити ветеринарні огляди, мити руки після контакту з тваринами та не дозволяти їм їсти сире м’ясо.
Чи можна повністю позбутися кишечной палочки
Цілком позбутися цієї бактерії неможливо, оскільки вона природно присутня в кишечнику. Проте можна контролювати її кількість і запобігати розвитку небезпечних штамів завдяки правильному харчуванню, гігієні та профілактиці.
Висновок про кишечную палочку
Кишечная палочка — це не завжди ворог. У нормі вона допомагає організму, але певні штами можуть бути небезпечними. Дотримання гігієни, уважність до симптомів і своєчасне звернення до лікаря допомагають уникнути ускладнень.
Читати далі: Розклад хвороб ВЛК – повний гід для призовників і військовослужбовців
Часті запитання про кишечную палочку
Кишечная палочка — це бактерія, яка живе у кишечнику людини, але деякі її види можуть викликати інфекції.
Зараження відбувається через брудну воду, їжу або контакт із хворими людьми.
Серед симптомів — біль у животі, діарея, нудота та підвищена температура.
Лікування включає рясне пиття, дієту, пробіотики та, у разі потреби, антибіотики за призначенням лікаря.
Потрібно мити руки, ретельно готувати їжу, уникати сирого молока та немитих овочів.
